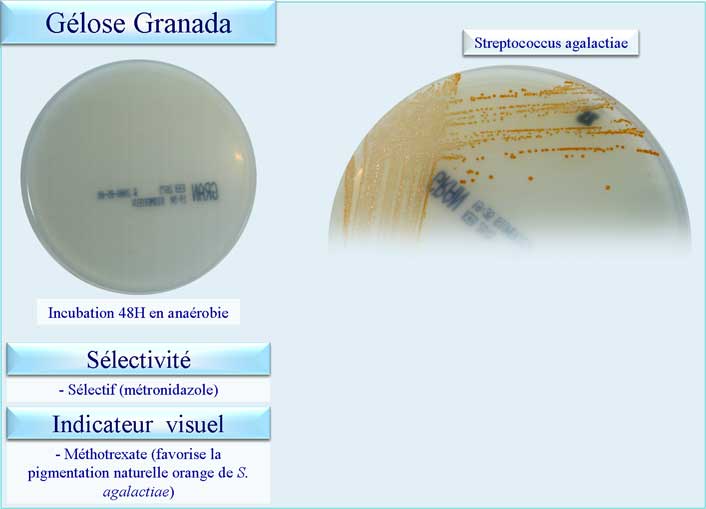
Gélose Granada
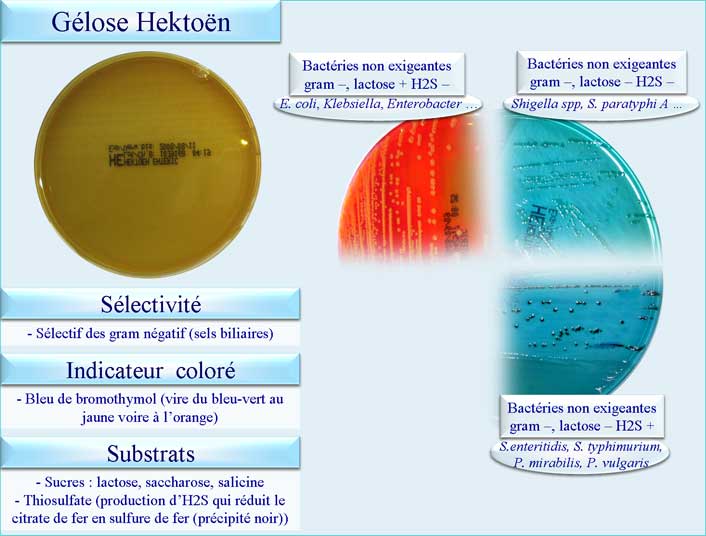
Gélose Hektoën
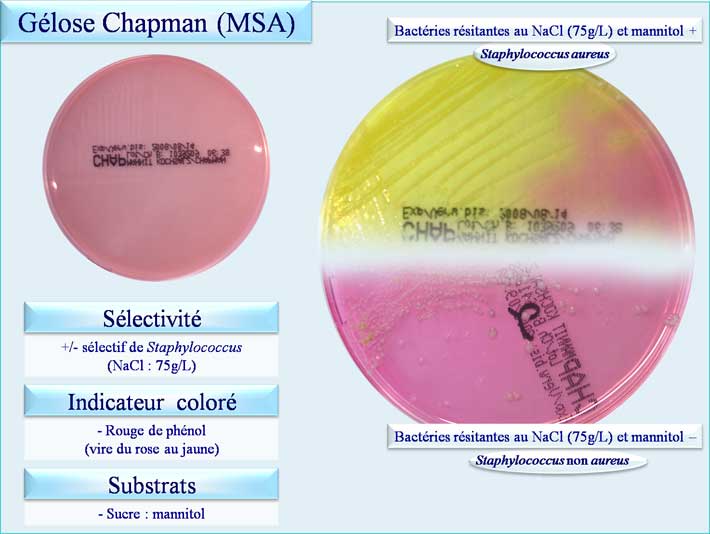
Gélose Chapman

Cliquez sur les icones correspondantes pour obtenir ces image en format haute définition (HD), en fichier Power Point 2003 (PPT2003) ou en fichier Power Point 2007 (PPT2007)
N'oubliez pas que l'utilisation de ces fichiers est soumise à des règles de copyright : ![]()
 Haute définition Haute définition |
 Power Point 2003 Power Point 2003 |
 Power Point 2007 Power Point 2007 |
Gélose BCP |
 |
Gélose Mac Conkey |
 |
Gélose Granada |
|
Gélose Hektoën |
|
Gélose Chapman |
|
|
|
   |
   |
   |